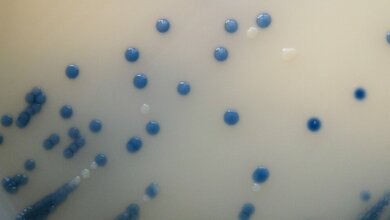
Gibt es Unterschiede zwischen Tag- und Nachtschicht?

Eine steigende Zahl von Studien beschäftigt sich mit dem Thema, ob Nachtschichten und das Krebsrisiko bei Frauen zusammenhängen. Es wurde deshalb Zeit, diese Studien insgesamt zu bewerten. Mit einer Meta-Analyse von 61 Artikeln wurden 114.628 Fälle und fast 4 Millionen Teilnehmerinnen aus Europa, Nordamerika, Asien und Australien erfasst.
Eine positive Korrelation wurde dabei für bestimmte Krebsarten gefunden. Das Erschreckende: Für alle 5 Jahre in der Nachtschicht stieg beispielsweise das Brustkrebsrisiko um 3,3%. Besonders betroffen waren Krankenschwestern.
Unter den längerfristig in der Nachtschicht arbeitenden Frauen stieg das Krebsrisiko insgesamt um 19 Prozent. Vor allem das Hautkrebsrisiko (+41 Prozent), Brustkrebsrisiko (+32 Prozent) und Krebs im Verdauungssystem (+18 Prozent) stiegen im Vergleich zu Frauen, die nicht längerfristig in der Nachtschicht arbeiten. Davon betroffen waren jedoch nur die Frauen aus Nordamerika und Europa. Ein Deutungsversuch liegt in Hormonunterschieden zwischen den Regionen.
Bei den Krankenschwestern lag das Risiko im Vergleich zu nicht in der Nachtschicht tätigen Frauen für Brustkrebs (+58 Prozent), Magenkrebs (+35 Prozent) und Lungenkrebs (+28 Prozent) sogar noch höher. Krankenschwestern in der Nachtschicht hatten sogar das höchste Risiko, an Brustkrebs zu erkranken unter allen Berufen, die analysiert wurden.
Damit hat dieser Review-Beitrag klar gezeigt, dass es eine Korrelation zwischen der Arbeit in der Nachtschicht und dem Risiko, an Krebs zu erkranken, gibt. Es wurde aufgezeigt, dass das Risiko mit der Anzahl der Jahre in Nachtschicht steigt. (AACR, red)
Xia Yuan, Chenjing Zhu, Manni Wang, Fei Mo, Wei Du and Xuelei Ma: Night Shift Work Increases the Risks of Multiple Primary Cancers in Women: A Systematic Review and Meta-analysis of 61 Articles. Cancer Epidemiol Biomarkers Prev; 27(1); 25–40, DOI: 10.1158/1055-9965. EPI-17-0221 Published January 2018.
Artikel teilen